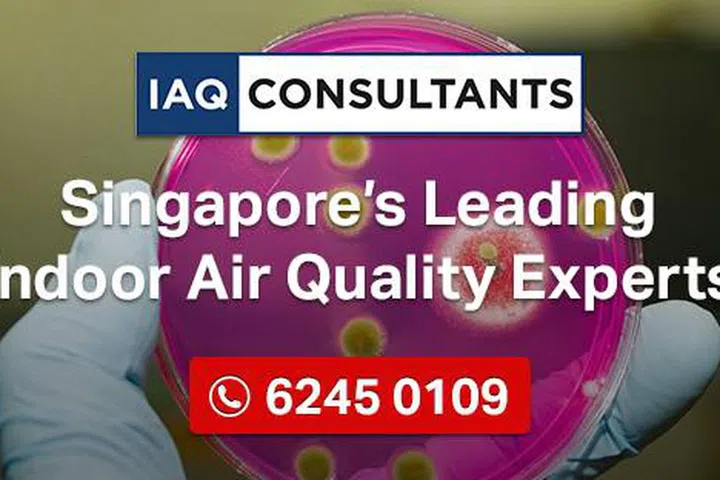

10 Formaldehyde Removal Services in Singapore
More homeowners opting for wood carpentry that are both aesthetically pleasing and cheaper.
By Kendra Tan -

In Singapore, purchasing your first Built-To-Order (BTO), resale flat, executive condominium (EC), or private housing is a significant milestone for many aspiring homeowners. And of course, to truly transform your new house into your dream home, renovation follows up as the natural next step.
However, beneath the excitement of new furnishings and fresh paint, lurked an invisible threat unbeknownst to homeowners — formaldehyde.
Commonly found in building products and household furnishings, it is used in resins and glues when constructing wooden furniture. This formaldehyde smell is better known as the “new house smell”. While formaldehyde might not present any salient health problems in small doses, formaldehyde side effects stemming from high levels of exposure can prove toxic and even, cancer-causing.
One such report by the Straits Times highlights Miss Aden’s plight battling burning sensations in her eyes, nose, throat, and shortness of breath after moving into her newly-renovated condo. Upon seeking medical attention, she was diagnosed with formaldehyde poisoning. In another CNA article, Ms Lee’s children reported constantly falling ill, with one bout of sickness lasting as long as two months.
Firms like HelpToClean and LAF Environmental, which specialise in indoor formaldehyde removal services, have reported an uptick in cases. The former saw a spike of up to 70 per cent and now handles about 80 cases per month on average. Meanwhile, the latter saw about 30 per cent more cases and manages more than 20 cases a month now.
This comes as more homeowners opt for wood furnishings that are both aesthetically pleasing and on the cheaper side.
What is formaldehyde?
Formaldehyde, also known as formalin, is a Volatile Organic Compound (VOC) that produces a colourless yet strong-smelling gas.
This toxic component is found in new building materials and household furnishings like artificial wood boards, glues and adhesives, wooden furniture, synthetic fabrics, emulsions like latex and paints, wall coverings, wallpapers, carpets, curtains, vinyl, and even new plastic.
How does formaldehyde affect health?
During home renovations, it’s notorious for emitting the “new house smell”, which can irritate the eyes, nose and throat and thereby, trigger asthma reactions, allergies, and headaches.
In more serious cases, severe formaldehyde poisoning from prolonged or high levels of exposure can cause severe systemic toxicity and lead to metabolic acidosis, tissue and organ damage, and even induce comas. They’ve also been linked to certain cancers like nasopharyngeal cancer, brain cancer, colon cancer, chromosomal abnormalities in newborns, leukaemia, and more.
What is the safety standard for formaldehyde in Singapore?
According to Channel News Asia, “a national safety standard applies for indoor air-conditioned spaces, where formaldehyde concentrations should be limited to 0.08 parts per million”.
How to get rid of formaldehyde after renovation?
- Increase ventilation: Formaldehyde can build up in indoor air, so increasing ventilation by opening windows and using fans can help reduce its concentration.
- Use air purifiers and bamboo charcoal air purifying bags: Air purifiers can help remove formaldehyde and other pollutants from the air. Look for models that use activated carbon filters, as these are effective at removing formaldehyde. Meanwhile, bamboo charcoal bags help to absorb and destroy formaldehyde pollutants in the air.
- Choose low-formaldehyde products: When buying new furniture, flooring, or other household items, choose products that have low levels of formaldehyde emissions. Look for products that are labelled as “low-VOC” or “formaldehyde-free.”
Pro-tip: To remove formaldehyde in your house, use plants! Certain plants, such as spider plants, peace lilies, and Boston ferns, can help remove formaldehyde from the air. Although limited in efficacy (unless you transform your home into an indoor jungle), adding some greenery to your home not only improves air quality but also adds a decorative touch.
- 1. What is formaldehyde?
- 2. How does formaldehyde affect health?
- 3. What is the safety standard for formaldehyde in Singapore?
- 4. How to get rid of formaldehyde after renovation?
- 5. LUMIAIR Singapore
- 6. LAF Environmental
- 7. EcoLife
- 8. UC Fresh Air
- 9. HelpToClean
- 10. IAQ Consultants
- 11. Home Guards
- 12. Pure Purification
- 13. Elelaurels
- 14. Air Pro
Bottom line is, if you’re a new homeowner worried about formaldehyde, it’s best to seek removal solutions from professionals. While the price may be high, your family’s health is priceless. That said, here are 10 formaldehyde removal services in Singapore to consider.

LUMIAIR Singapore
LUMIAIR is an expert in decontamination, providing solutions for mould, mildew, and formaldehyde problems. Boasting a roster of skilled professionals, each consultant, specialist, and technician undergoes 147 hours of in-house and on-site training to ensure their skills and expertise remain up-to-date.
Overall, their team delivers comprehensive and customised removal services utilising state-of-the-art technology such as negative air machines and air scrubbers to capture and remove airborne contaminants. Exclusive ozone blasting to effectively eliminate odours. Sanitisation, disinfection, and antimicrobial treatments to prevent the resurgence of micro-organic growth. Ultraviolet germicidal irradiation (UVGI) to eradicate bacteria, mould, and viruses.
Contact +65 6741 3777 or visit the Lumiair website.

LAF Environmental
LAF Environmental is another leading expert for air purification services, offering a myriad of quality sustainable solutions like formaldehyde (VOC) removal, odour control, aircon services, air duct sanitation, and more.
As an authorised dealer of IQAir purifier products and an RGF distributor in air purification, they are equipped to tackle air pollution by removing particulates (e.g. dust, pollen), microbes (e.g. bacteria, viruses, moulds), and gases (e.g. formaldehyde).
In particular, their formaldehyde removal service can promptly eliminate toxic contaminants and pungent odours, prevent outgassing of formaldehyde from wood furnishings, activate carbon for the most effective formaldehyde removal, 100% natural fragrance gel to decompose formaldehyde odour, free pre- and post-service test reports to compare gas emission levels.
Contact +65 6506 7336 or visit the LAF Environmental website.

EcoLife
EcoLife is an established formaldehyde removal and disinfection expert for indoor spaces. They pride themselves on handling all sorts of formaldehyde removal services, be it your home, your office, or even your car! Committed to delivering high-quality, robust tailor-made solutions, their services include thorough consultations, onsite formaldehyde inspection, effective formaldehyde removal processes, and detailed follow-up care.
Not to mention, they even sell a catalogue of formaldehyde-removal products from Taiwan containing natural chitin – an organic compound capable of decomposing and absorbing 99.9% formaldehyde, benzene, ammonia, VOC, and other harmful substances efficiently.
If you’re interested, check out these products under their Homegreen series, namely the Ecoguard Furniture Spray, Ecoguard Furniture Wax, Ecoguard Floor Wax, Ecoguard Chitosan Paint
Contact +65 9180 2908 or visit the Eco Life website to get a quote.

UC Fresh Air
Specialising in indoor air treatment, UC Fresh Air is dedicated to providing holistic air quality assessments and purification services.
Leveraging certified equipment and lab-tested products imported from Japan, UC Fresh Air delivers on their promise through precise detection and analysis to treat formaldehyde, benzene, total volatile organic compounds (TVOCs), and other harmful airborne pollutants.
So if you need targeted formaldehyde and TVOC removal, antibacterial coating, and/or deep disinfection services, you know who to call.
Contact +65 6697 4964, SMS or Whatsapp +65 9070 5064 or visit the UC Fresh Air website.

HelpToClean
To decide the best formaldehyde removal solutions, HelpToClean will individually assess each case’s formaldehyde pollution based on a few factors, namely the severity of formaldehyde pollution, environmental condition of formaldehyde pollution, specific pollutants involved, and the homeowner’s personal preferences and desired outcome
Here’s a look at the overall flow of their formaldehyde removal process:
Step 1: Arrange a site assessment with their IAQ Specialist.
Step 2: Test initial amount of formaldehyde contaminating air using a state-of-the-art detector device.
Step 3: Proceed with air purification and VOC decomposition, seal materials, and conduct advanced protection.
Step 4: Perform a re-test after seven days to monitor the decrease in formaldehyde levels in the air.
Step 5: Ensure safety to move in once readings are within safe levels.
In general, HelpToClean believes in utilising a combination of formaldehyde removal methods — absorption, capturing, and decomposition — instead of relying on just one for more comprehensive and guaranteed results. Receive a complimentary service within one year if your home/office’s formaldehyde level reaches unacceptable levels (> 0.08 ppm).
Contact +65 9005 7764 or visit their website.
IAQ Consultants
Suspect your home or office space might be plagued by formaldehyde pollution? Then it’s time to call the experts in for an assessment. At IAQ Consultants, their specialists are trained and comply with the best IAQ testing Code of Practice (SS554) to ensure your indoor air quality at home is safe and healthy.
Through the help of their in-house labs, IAQ Consultants can generate proposals, test, and provide accurate testing results efficiently upon request for instances like suspected indoor formaldehyde pollution. Thereafter, they’ll work closely with you to investigate, measure, diagnose, and offer mitigation measures to remove traces of formaldehyde contamination as swiftly as possible.
Contact +65 6245 0109 or visit the IAQ Consultants website.
Home Guards
While formaldehyde cannot be eliminated instantly and requires several years to decompose, Home Guards offers several customisable formaldehyde removal solutions designed to mitigate and significantly reduce toxic formaldehyde emissions. These treatments are available in photo and non-photocatalyst applications.
For instance, one such approach comprises applying sprays and coatings onto surfaces emitting formaldehyde, effectively lowering the initial concentration to safer levels. Over time, the formaldehyde will break down, allowing you to continue living in your home with peace of mind.
WhatsApp +65 8687 0211 or visit the Home Guards website.

Pure Purification
At Pure Purification, they’ll walk you from start to finish to ensure that your future home is free from formaldehyde poisoning.
Their service procedures encourage both attention to pre-renovation and post-renovation steps. Before renovation, your home should be clean, dust-free, and properly ventilated. Subsequently, they will follow up with the application of professional-grade equipment such as KARCHER from Germany and GRAFTON from Japan to remove formaldehyde from surfaces and indoor air as effectively as possible.
Contact +65 9196 0971 or visit the Pure Purification website.

Elelaurels
Elelaurels’ professionals use exclusive formaldehyde removal products and treatments from Japan. In particular, their unique LiveCoat treatment leverages Japan’s advanced photocatalyst technology to efficiently decompose formaldehyde molecules — removing both strong smells and any traces of it.
But how does this differ from other usual formaldehyde removal brands?
Moreover, their photocatalyst approach is particularly anti-bacterial, anti-fouling, anti-moulding, and has a lasting deodorising effect to remove all sorts of odours in the long run. Its disinfection power is much stronger than commonplace alcohol, chlorine, or ozone products and longer-lasting overall.
Contact +65 8224 2252 or visit the Elelaurels website.

Air Pro
Last but not least, Air Pro is a seasoned pro in the air disinfectant industry — and their comprehensive formaldehyde and VOC removal procedure is a testament to that. Prioritising both the client’s safety and comfort, they provide both pre-treatment and post-treatment assessments on top of the purification process itself. Here’s a breakdown of what their treatment entails:
Step 1: Onsite air quality assessment. An air quality specialist will be deployed on-site to identify potential sources of formaldehyde and VOCs using an air quality metre.
Step 2: Pre-treatment preparation. All electrical appliances and valuables (e.g. art pieces, antiques, collectables) will be covered. Other furniture like drawers, cabinets, and VOC-prone items will also be removed.
Step 3: Formaldehyde and VOC removal. An ultra-low volume (ULV) misting of the formaldehyde-removal chemical will be employed to ensure that all surfaces, crevices, and hard-to-reach places are generously disinfected.
Step 4: Post-treatment assessment. Upon treatment completion, their air quality specialist will conduct a follow-up assessment. Pre- and post-treatment air quality readings will be shown to confirm that air quality is now at a safe level.
Contact +65 8807 6335 or visit the Air Pro website.
How much does formaldehyde removal cost in Singapore?
Many sites we searched don’t have a price, so you’ll have to contact them to get a personal quote. However, according to online reports, formaldehyde removal services can cost almost S$1,000.
Will the formaldehyde removal service eliminate every trace of formaldehyde?
No. Formaldehyde emissions can be extremely stubborn to deal with, with some taking as long as 15 years to fully break down and dissipate even with proper ventilation and products. Indoor formaldehyde levels are also affected by external factors daily, such as receiving new parcels, buying new furniture, neighbours renovating etc.
While formaldehyde cannot be eliminated instantly, what does help is enlisting the help of formaldehyde removal professionals to reduce toxic formaldehyde levels significantly. By applying proper formaldehyde removal treatments, the chemicals will help to break down formaldehyde gradually and decrease formaldehyde levels in the air over time.
That said, maintaining good ventilation and possibly repeated treatments remains essential to ensure that formaldehyde levels remain low and within the safe range.
Is there a DIY solution for formaldehyde removal?
If your household is combating formaldehyde issues too, you may be tempted to use several DIY methods for formaldehyde removal. However, these only offer temporary or partial solutions.
For instance, formaldehyde removal gels and activated charcoal are often suggested as DIY solutions to eradicate formaldehyde smells and can be easily bought on e-commerce platforms like Shopee. However, users have reported these products as ineffective.